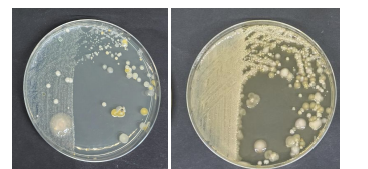

Laxton Junior School Takes Part in the National Swab and Send Programme
As part of British Science Week, our Year 6 pupils at Laxton Junior School had the extraordinary opportunity to contribute to real, impactful scientific research through the Swab and Send project, led by Professor Roberts and the team at the Liverpool School of Tropical Medicine (LSTM). This isn’t a classroom simulation. Swab and Send exists for one powerful purpose: to help scientists discover the next generation of antibiotics, before the medicines we rely on stop working.
Antibiotic resistance is a growing global health emergency. When antibiotics fail, common infections become dangerous; routine surgery becomes high‑risk; and illnesses we take for granted could once again become life‑threatening. The search for new antimicrobial compounds is urgent and surprisingly, promising candidates can sometimes be found in the most everyday places.
Our Year 6 pupils have played a small but meaningful part in that search.
What Did Year 6 Do?
Pupils collected swab samples from locations across school, everything from door handles, lockers and sports equipment to soil, moss, plants and musical instruments. These were sent to LSTM, where scientists

-
cultivated the microbes on agar plates
-
selected unusual or interesting colonies
-
preserved them in 96 well plates at –80°C
-
and screened them against five indicator species
LSTM looked for “zones of inhibition”: clear areas where a microbe successfully killed or stopped the growth of harmful bacteria and fungi. These zones indicate microbes that may be producing antimicrobial compounds. Exactly the type of compounds the world urgently needs.
The Results: Our Pupils Made Real Scientific Discoveries
Across all samples, LSTM isolated over 300 microbial colonies, with 35 showing antimicrobial activity. These “hit isolates” are now being stored for deeper analysis as part of the ongoing national research effort.
Some standout highlights:
Most Diverse Sample
Daniyal’s swab, taken from the floor, contained 14 different microbial species – the highest diversity across all samples.
Most Potent Microbe
James E’s swab, taken from outdoor equipment grew a microbe that successfully inhibited all five indicator species, a result that particularly excited the LSTM scientists.
Pupils with antimicrobial “hits”
Amelia T, Huzayfa, Ellas, Daniyal, Immy, Olivia, Otto, Maher, Joshua, Sebastian, Hugo, James E, Ewan, Millen, Declan, Oliver, Quentin and Margot all collected samples containing microbes with antibacterial or antifungal activity.
These results are not just interesting, they’re scientifically valuable.
Why This Matters: The Antibiotic Crisis
The World Health Organisation lists antimicrobial resistance as one of the biggest threats to global health. Existing antibiotics are becoming less effective each year. Scientists urgently need new sources of antimicrobial compounds, and nature remains one of the most promising places to look.
Projects like Swab and Send allow pupils to contribute directly to this mission by helping identify microbial strains that may one day form the basis of new treatments.
Our pupils’ samples contained several promising isolates now being held for further research. This means that something collected from a door handle, leaf, railing or even a book could in the future inform the development of novel antimicrobial agents.
That’s an extraordinary outcome for pupils of primary age and a testament to the power of early science education.
Thank You to LSTM – and Well Done, Year 6
We extend a huge thank you to Professor Roberts and the Swab and Send team for their enthusiasm, expertise and for sharing such detailed findings with us. Their excitement about our pupils’ results highlights how meaningful these contributions are.
We would also like to extend our thanks to Mrs Lisa Smith, our Head of Science, whose passion and expertise were central to the success of this project. Mrs Smith brings science to life every single day at Laxton Junior School sparking curiosity, encouraging bold questions, and inspiring children from as early as Year 2 to see themselves as real scientists. As well as our own on-site science laboratories at Laxton Junior School, we also have access to SciTec in Oundle – a groundbreaking science complex that houses state-of-the-art laboratories and facilities for Mathematics, Science, and Design, Engineering & Technology.
Her energy and commitment ensured that our Year 6 pupils approached Swab and Send with excitement and confidence, fully understanding the importance of their contribution to the global search for new antibiotics. Thanks to her leadership, our children not only learned how science works, but why it matters and that their discoveries can make a genuine difference in the world.
What a powerful way to mark British Science Week: real science, real impact, and real hope for the future.




